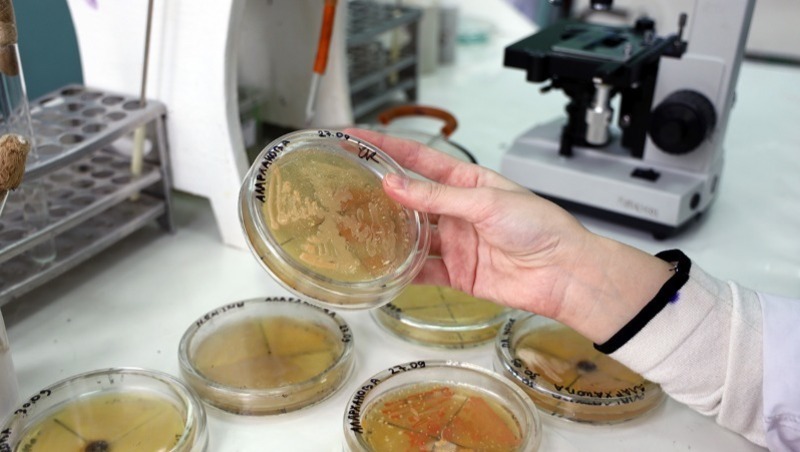

Учёный-химик АГТУ Дарья Бурмистрова изобрела уникальный метод борьбы с токсичными веществами в нефтегазовом производстве при помощи электролиза и в начале 2022 года получила грант президента РФ за данную разработку. Метод астраханки в два раза экономичнее по показателям энергоэффективности, а в результате переработки получаются ценные органические соединения — несимметричные дисульфиды, применяемые в фармацевтической отрасли и сельском хозяйстве.


Кстати, в этом же году, правда, уже в ноябре, коллеги Дарьи по цеху открыли новый вид бактерий для очистки водоёмов от нефтяных загрязнений. Полученные микроорганизмы избавят акваторию Каспийского моря от нефтепродуктов и увеличат отдачу нефтяных пластов.

Другая наша землячка — школьница Диана Гафурова — создала инновационный протез кисти руки. Устройством можно управлять через мозговой интерфейс, причём использование протеза не требует никаких хирургических вмешательств. Разработка астраханской ученицы заинтересовала учёных из Сколково!


А изобретение, созданное в 2022 году астраханцем Кириллом Бариновым, поможет справиться с нервным тиком. На данный момент собран полноценный функционирующий прототип и разработана основная логика программы.
Позаботились юные жители Астраханской области и о детях с проблемами позвоночника. Учащиеся Регионального школьного технопарка разработали и представили прототип умного корсета для исправления тяжёлой формы сколиоза.


И это не все юные таланты нашего региона — Астрахань вообще богата на новых Королёвых и Курчатовых. Так, выпускники Центра одарённых детей помогают осваивать космическое пространство. Вместе с другими воспитанниками знаменитого «Сириуса» они разработали первый зондовый микроскоп, который скоро запустят на орбиту.


Кто-то работает над одним научным проектом, а кто-то создаёт целую линейку высокотехнологичного оборудования. Разработчики из Астраханского госуниверситета открыли собственную компанию SMELCOM ROBOTICS и теперь производят различные подводные робототехнические комплексы. Их роботы могут проводить мониторинг водоёмов, выполнять строительные и гидротехнические задачи в подводной среде и даже добывать полезные ископаемые с морского дна.


В этом году наши учёные также провели изучение водных биологических ресурсов Каспийского моря с использованием исследовательского судна. Теперь им предстоит обработать собранные материалы и дать оценку биологического состояния экосистемы и продуктивных свойств всей трофической цепи Северного и Среднего Каспия.
И напоследок, как говорится, новое время требует новых решений. Астраханец создал инновационный бронежилет, в качестве защитного материала которого выступает неньютоновская жидкость. Она рассеивает силу удара и снижает вероятность получения ранения, образуя так называемый «тупой удар». Поэтому обмундированию не страшна ни одна пуля.